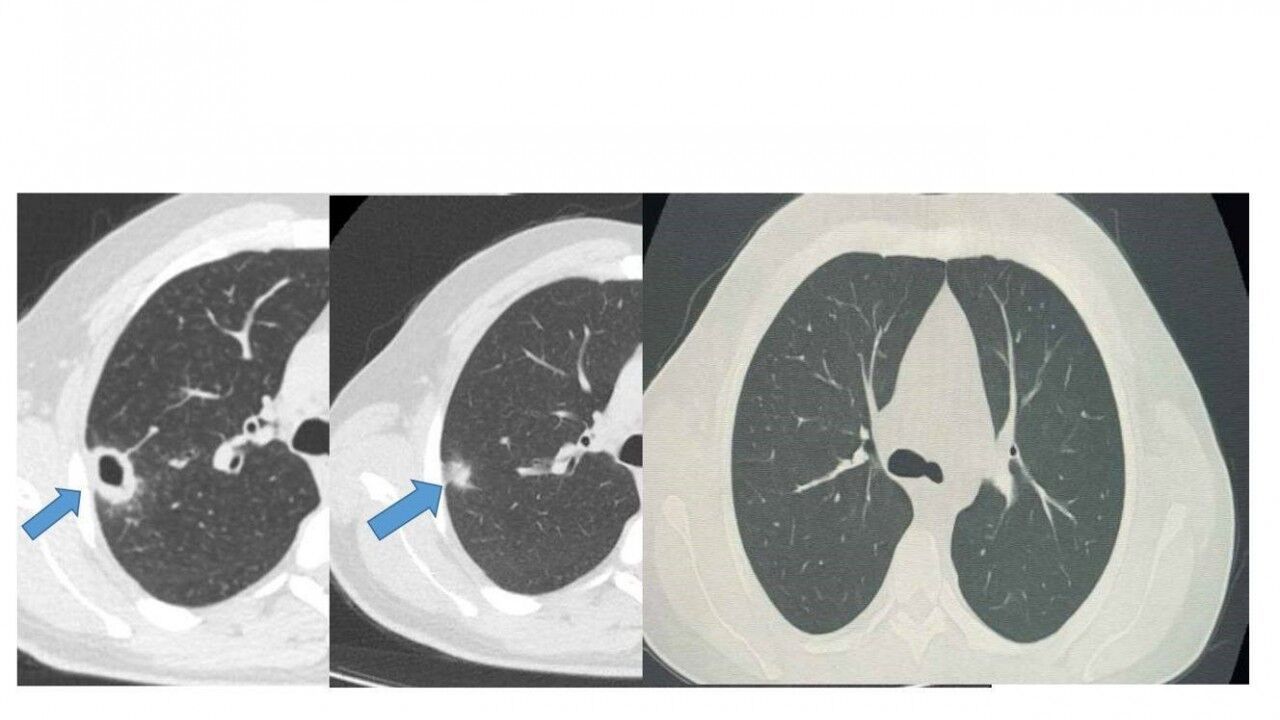

Bayburt Devlet Hastanesine öksürük ve balgam şikayetiyle başvuran 50 yaşındaki hastanın akciğerinde kitle benzeri bir doku tespit edildi. Yapılan tetkikler sonucu ciddi bir hastalık olmadığı belirlenen hasta, erken tanı ve doğru tedavi sayesinde sağlığına kavuştu.
Göğüs Hastalıkları Uzmanı Uzm. Dr. Hilal Sayma tarafından muayene edilen hastaya ileri tetkik amacıyla bronkoskopi işlemi uygulandı. Bronkoskopi sonucunda lezyonun kanser veya tüberküloz gibi ciddi hastalıklarla ilişkili olmadığı belirlenerek, hasta için uygun tedaviye başlandı.
İki haftalık tedavi sürecinin sonunda yapılan kontrollerde lezyonun neredeyse tamamen gerilediği görüldü. Sağlığına kavuşan hastanın taburcu edildiği ve durumunun iyi olduğu öğrenildi.
Kaynak: İHA